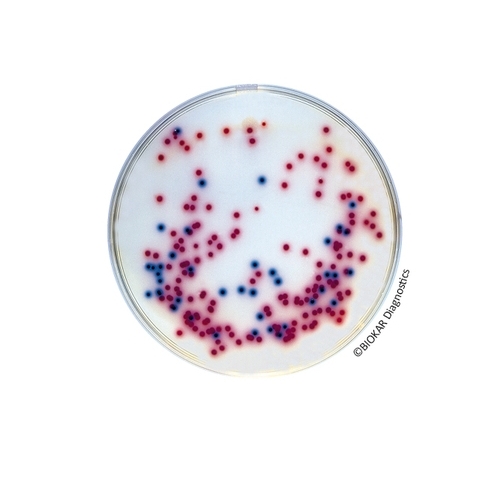
COMPASS® Salmonella Agar

COMPASS® Salmonella Agar
COMPASS® Salmonella Agar is a selective media allowing the isolation and differentiation of bacteria belonging to the genus Salmonella. It can be used as the second media in all normalized and validated methods for the detection of Salmonella. COMPASS® Salmonella Agar is also used in the context of the rapid alternative method for the detection of Salmonella (SESAME Salmonella TEST®).
| Ürün Adı | COMPASS® Salmonella Agar |
| Ürün Kodu | BM06608 |
| Miktar | 20 Petri plates Ø 90 mm |